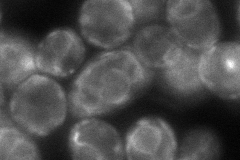
YOR198C
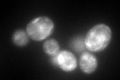
YOR198C

View description
Component of mRNP complexes associated with polyribosomes; implicated in secretion and nuclear segregation; multicopy suppressor of BFA (Brefeldin A) sensitivity
Localization:
Intensity:
Fold change:
Significance:
-
C’ GFP library in SD

ER86.71 -
N' NOP1pr-GFP in SD

vacuole membrane312.696 -
N' TEF2pr-mCherry in SD

cytosol381.659 -
N' NATIVEpr-GFP in SD
ER105.395 -
N' TEF2pr-VC and Cyto-VN in SD

#N/A0 -
C’ GFP library in SD+DTT
ER137.31.58Yes -
C’ GFP library in SD+H2O2

ER74.090.85No -
C’ GFP library in Starvation Media

ER37.040.42Yes -
C’ GFP library on the background of Pup2-DaMP

ER -
C’ GFP library on the background of CCT mutant

ER86.71831No
